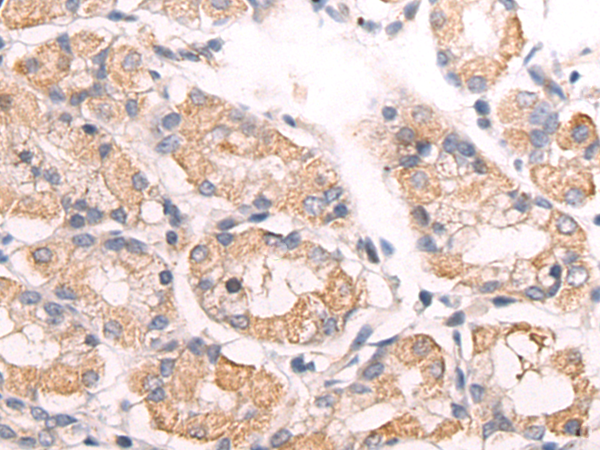
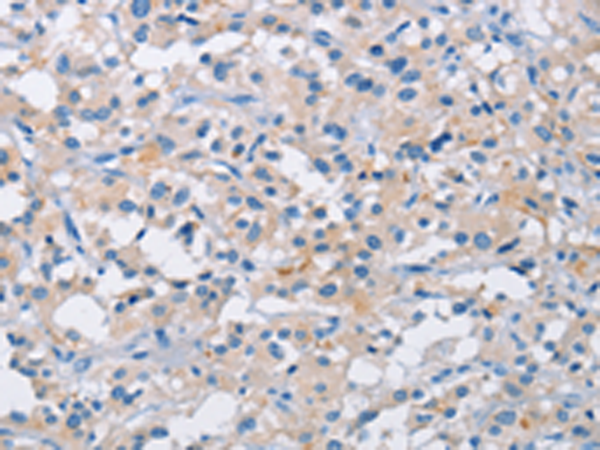
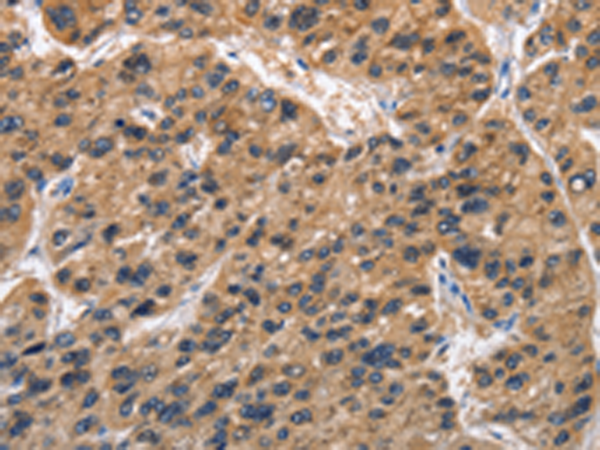

-
分类: 科研抗体货号: P08047别名: ARLTS1应用: IHC反应种属: Human
-
分类: 科研抗体货号: P08058别名: ATX1; SCA1; D6S504E应用: WB,IHC反应种属: Human, Mouse, Rat
-
分类: 科研抗体货号: P08039别名: FSGS; FSGS1; ACTININ-4应用: WB,IHC反应种属: Human, Mouse, Rat
-
分类: 科研抗体货号: P08045别名: PA; AMY2; AMY2B应用: WB,IHC反应种属: Human, Mouse
-
分类: 科研抗体货号: P08057别名: M8-9; MRXE; XMRE; HT028; ELDF10; ATP6IP2; MSTP009; APT6M8-9; ATP6M8-9应用: IHC反应种属: Human, Mouse, Rat
-
分类: 科研抗体货号: P08038别名: TARSH; NESHBP应用: IHC反应种属: Human
-
分类: 科研抗体货号: P08073别名: BLAME; CD353; SBBI42应用: IHC反应种属: Human
-
分类: 科研抗体货号: P08054别名: ACL; ATPCL; CLATP应用: WB反应种属: Human, Mouse, Rat
-
分类: 科研抗体货号: P08037别名: DSPS; SNAT应用: IHC反应种属: Human, Mouse, Rat
-
分类: 科研抗体货号: P08072别名: SLO; BKTM; SLO1; MaxiK; SAKCA; mSLO1; KCa1.1; SLO-ALPHA; bA205K10.1应用: IHC反应种属: Human

鄂公网安备42018502007531号
鄂公网安备42018502007531号

